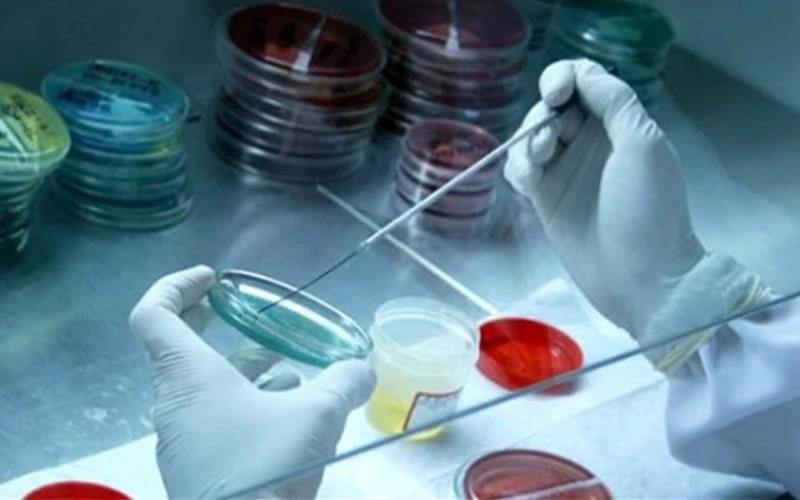
Verificação de Métodos e Cálculo de Incerteza para Microbiologia

Treinamentos
- Home
- Laboratórios
- Controle de Qualidade Microbiologia Matriz Àgua
Técnicas de Amostragem para Água e Efluentes
31 de março de 2023Interpretação e Aplicação da ABNT NBR ISO/IEC 17025:2017
31 de março de 2023Carga horária: 8 horas
Horário: 18:30 às 22:30h
Tipo de Curso: Online Ao Vivo
Plataforma: Microsoft Teams
Instrutora: Flávia Isabel
Graduada em Engenharia de Alimentos pela Universidade Federal de Goiás (2003), especialização em Tecnologia e Qualidade de Alimentos de Origem Vegetal pela Universidade Federal de Lavras (2007), mestrado em Ciência e Tecnologia de Alimentos pela Universidade Federal de Goiás (2007) e MBA em Gestão de Pessoas por Competências, Indicadores e Coaching pelo IPOG (2019).
Tem experiência em microbiologia, tanto de alimentos quanto de cosméticos, onde atuou como analista, coordenadora, gestora de equipe. Possui conhecimento e experiência na ISO 17025.
Teve grande atuação na área de Educação, com ênfase em Ensino-Aprendizagem, atuando principalmente nos seguintes temas: Tecnologia e Microbiologia. Auditora de gestão e de ensaios microbiológicos.
Cronograma:
- ISO 17025: Requisitos gerais para a competência de laboratórios de ensaio e
calibração; - ISO 11133: Microbiologia de alimentos, ração animal e água – Preparação,
produção, armazenamento e teste de desempenho de meios de cultura; - SMWW: Standard Methods for the Examination of Water and Wastewater
- Princípios gerais e conceitos;
- Controles de qualidade interno:
- Ambiental;
- Equipamentos;
- Meios de cultura e reagentes;
- Controle de qualidade externo;
- Ensaio de proficiência;
- Apresentação de casos e problematização.
Material fornecido:
- Material de apoio para o treinamento;
- Certificado de participação.
Informações sobre o Pagamento / Acesso ao Treinamento:
- Assim que o treinamento for confirmado, enviaremos a solicitação do pagamento (boleto, pix ou link para cartão de crédito), conforme opção escolhida pelo participante.
- Formas de Pagamento: No Cartão de Crédito (em até 6x) ou no Boleto/Pix com 5% de desconto.
- A confirmação do Treinamento é enviada em até 2 (dois) dias antes da data programada do treinamento.
- As informações de acesso e o material de apoio serão enviados ao e-mail cadastrado em até um dia antes do treinamento.
Produtos relacionados
-
Solicitar cotação
Definição de Critérios para Calibração
Datas:
-
Turma: 14 a 15 de Maio;
-
-
Solicitar cotação
Verificação de Métodos e Cálculo de Incerteza para Microbiologia
Datas:
-
Turma: A definir;
-
-
Solicitar cotação
Controle de Qualidade da Água para Hospitais
Datas:
-
Turma : 3 de Junho;
-
Avaliações
Não há avaliações ainda.